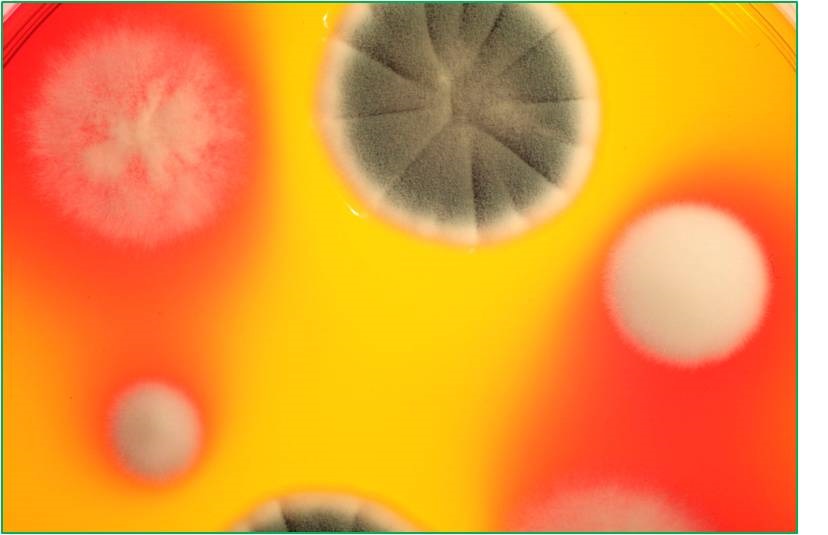
真菌毒素 真菌毒素

真菌毒素又稱霉菌毒素,是某些霉菌在生長繁殖過程中于一定環境下產生的二次代謝有毒產物,是飼料的主要污染物之一。真菌毒素按產毒素的菌種主要分為曲霉菌毒素���、鐮刀菌毒素、青霉菌毒素等幾大類�。通過牛奶的消化和代謝����,真菌毒素以原型或者代謝產物的形式進入乳品中,人類攝入含真菌毒素的乳品會引起急性或慢性中毒���,長期攝入含真菌毒素的乳品會帶來嚴重危害�,主要表現為致癌性、遺傳毒性和致畸性等��。其中黃曲霉毒素B1的毒性����、致癌性、污染頻率均居首位���,是已知毒性最強的天然物質之一�����,已被國際衛生組織國際癌癥研究總署確認為A類致癌物質����。因此國內外紛紛制定法律法規對食品中真菌毒素的殘留情況進行限制��。國家標準GB2761-2011中對真菌毒素在食品中的殘留情況進行了限定。目前乳制品中真菌毒素殘留主要集中在黃曲霉毒素�、玉米赤霉烯酮����、嘔吐毒素等�。
飛測生物率先在國內推出乳品中真菌毒素系列熒光定量免疫層析檢測產品�,具有靈敏度高��,操作簡便、結果準確��、重復性好等優點��,通過便攜式熒光讀數儀判讀�����,可以給出定量或者定性的檢測結果��,避免人為判讀帶來的誤差�。
產品編號產品名稱類型規格